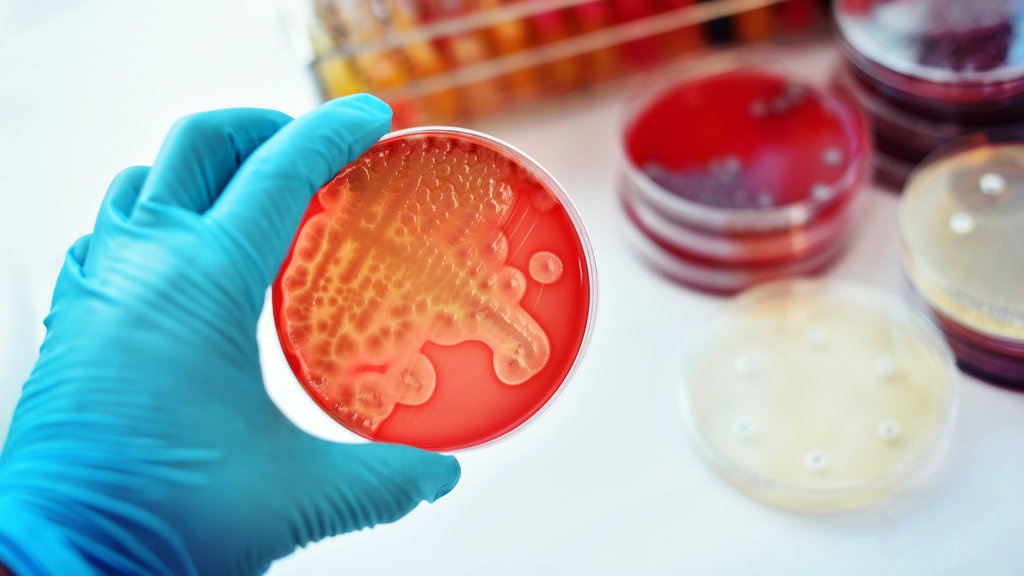
Mengapa Gonorea/Penyakit Kencing Nanah Merebak Lagi? Mengapa Gonorea/Penyakit Kencing Nanah Merebak Lagi?

tirto.id - Penyakit gonorea dikabarkan kembali merebak.
Analisis WHO terhadap 77 negara menunjukkan 78 juta orang di seluruh dunia terkena penyakit yang menular secara seksual ini—sebagian besar tinggal di negara-negara miskin. Seperti dikutip BBC pada 7 Juli 2017, WHO melaporkan bahwa resistensi gonorea terhadap antibiotik meluas.
Penyakit gonorea bersumber dari peradangan yang disebabkan oleh infeksi bakteri N. gonorrhoeae, yang tersebar melalui kontak tanpa pelindung dengan penis, tenggorokan, atau vagina. Gonorea bisa berdampak kemandulan dan meningkatkan resiko infeksi HIV.
Berita dari BBC merupakan kabar termutakhir tentang mewabahnya penyakit lawas yang pernah menimbulkan kepanikan moral di Barat pada abad 19 dan telah berhasil diatasi sepanjang abad 20. Pada 1997, gonorae meledak di Kanada. Pada 2009, 10 ribu orang per tahun dilaporkan terkena gonorae. Di Amerika Serikat, gonorae adalah penyakit menular seksual kedua yang paling populer setelah klamidia.
Di Swedia, gonorea sempat berjaya pada tahun 1970-80an. Namun, seperti dilaporkan sifilis, dalam satu dekade terakhir terakhir, 1.232 kasus gonorae dilaporkan di Swedia.
Dilansir Deutsch-Welle, pada 2013 Robert Koch Institute memperkirakan jumlah infeksi di Jerman sebanyak 10.000 dan 20.000 per tahun tahun. Deutsch-Welle juga menyebutkan bahwa seluruh penyakit menular seksual tiba-tiba mewabah.
Penyakit-Penyakit Lawas yang Bangkit
Penyakit menular secara seksual telah dikonstruksi secara kultural selama berabad-abad sebagai bahaya moral. Beberapa kalangan mengajukan solusi yang sama, yakni memperketat moralitas, mempromosikan kesalehan publik, serta menutup tempat-tempat prostitusi.
Oleh sebab itu, seringkali penyakit seksual menjadi komoditas politik.
Namun, merebaknya gonorea hanyalah satu fenomena dari kebangkitan penyakit-penyakit lawas yang telah diberantas. Pun, sebab mengapa penyakit-penyakit ini kembali muncul ternyata lebih kompleks dan variatif ketimbang perkara moral. Kampanye anti-vaksin, pemanasan global, kebijakan pemerintah, hingga industri farmasi merupakan beberapa di antara banyak faktor.
Penyakit sifilis, misalnya, kembali mewabah di negara bagian Maine, Amerika Serikat baru-baru ini. Kurangnya pengetahuan tentang seks yang aman menjadi faktor penyumbang. Gerakan anti-vaksin membuat penyakit yang sebetulnya bisa disembuhkan dan dicegah dengan mudah seperti Pertusis, campak, polio, cacar air kembali marak.
Baca:
- Tolaklah Vaksin, Penyakit Kau Tangkap
- Bagaimana Gerakan Anti-vaksin Mendunia?
- Perang Argumen Anti-vaksin dan Pro-vaksin
Miskin Riset dan Resistensi Antibiotik
Pada 11 Juli lalu, BBC melaporkan keberhasilan ujicoba vaksin gonorae. Upaya ini ditempuh akibat gonorae semakin kebal antibiotik yang pada akhirnya memunculkan bakter jenis baru “super-gonorea. Minimnya minat industri farmasi terhadap riset-riset antibiotik adalah faktor penting yang menyumbang pada lahirnya gonorea yang kebal obat. Padahal, antibiotik perlu diperbaharui terus-menerus.
“Pada dekade 1980an, kita menyaksikan puluhan antibiotik baru. Tapi sekarang kita cukup beruntung dengan kemunculan satu atau produk baru,” tulis Elizabeth Sukkar dalam Pharmaetical Journal pada 2013. Industri obat tidak terlalu tertarik untuk berinvestasi di riset-riset antibiotik karena sedikitnya laba yang dapat diraup.
"Biaya uji cobanya tinggi dan masyarakat tak bersedia untuk membayarnya. Hasilnya paradoks, orang ingin antibiotik murah, tapi ongkos pengembangannya tinggi,” ujar Mahesh Patel, direktur penelitian obat-obatan di Wockhardt, perusahaan farmasi yang berbasis di Mumbai, India.

Penggunaan antibiotik tanpa regulasi juga menimbulkan masalah. Di beberapa tempat, obat ini dipandang sebagai obat segala obat infeksi. Sara Reardon menulis untuk Nature, menyebutkan bahwa di Cina, rumah sakit dan klinik mendapatkan insentif untuk tiap resep yang dikeluarkan untuk pasien. Akibatnya, konsumsi antibiotik naik drastis. Belum lagi ongkos dokter yang tinggi membuat orang beralih ke antibiotik. Mereka membelinya tanpa resep.
“Beberapa negeri mengizinkan penjualan antibiotik tanpa resep, dan orang mengkonsumsinya bahkan untuk penyakit-penyakit yang tidak bisa disembuhkan oleh antibiotik seperti malaria,” tulis Reardon.
Tak hanya gonorea, TBC pun kembali menjadi ancaman karena penggunaan antibiotik yang sembarangan. Selasa lalu (18/7), Al-Jazeera melaporkan jumlah penderita TBC meningkat di dari 2,2 juta di tahun 2014 ke 2.8 juta pada 2015. Jenis bakteri TBC pun yang resisten terhadap antibiotik pun berkembang. India tercatat sebagai negara dengan tingkat penderita TBC terbesar di dunia. Menyusul di belakang India adalah Indonesia, China, Nigeria, Pakistan, dan Afrika Selatan.
Indonesia termasuk rawan dalam hal penyalahgunaan antibiotik. Penelitian Ivan S. Pradipta, dkk, tentang puskesmas yang diterbitkan di Journal of Family and Community Medicine pada 2015, menunjukkan bahwa penggunaan antibiotik seringkali ditentukan oleh tingkat pengetahuan pembuat resep, kesulitan diagnosis, tekanan pasien, serta kondisi keuangan. Sementara itu di puskesmas, jumlah tenaga ahli seperti dokter umum, spesialis dan ahli farmasi sangat terbatas.
Penulis: Windu Jusuf
Editor: Maulida Sri Handayani
Masuk tirto.id